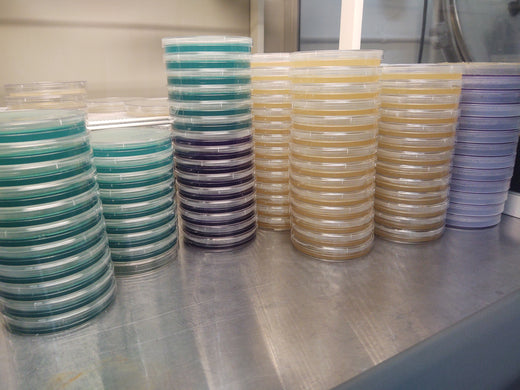
Pre-Poured Agar dish, MEA formulation 10 pack

Laminar Flow HEPA Filter

Premium HEPA filter
CNC Plasma-cut Aluminum Housing
True Laminar Flow
Long Lifespan
110 Volts
Made in USA

HIGH QUALITY
Captures 99.97% @ of airborne particles down to .3 microns. Uses commonly available replacement filter AP1518 for easy replacement.

PERPETUAL DISCOUNT
Upon purchasing this unit, a discount code will be activated for your customer account. You will receive 15% OFF our agar products as often as you wish.

OPTIONAL COVER
Front protective cover that doubles as an elevated work surface. This cover protects the delicate filter during storage or transport.
Product Specs






SO … WHAT ARE
YOU WAITING FOR ?
Lower contamination rates await!
Related Products
Mycology-Supply Model 1 Flow Hood Optional Cover & Workspace
Optional front protective cover that doubles as an elevated work surface to keep your materials and tools in the clean air flow. This cover protects the delicate filter during storage or transport. This is for our Model 1 Flow Hood. Measures 13"x15"x2".
NOTE: THIS IS A COVER ONLY and NOT THE ACTUAL FLOW HOOD FILTER UNIT.
Made in USA.